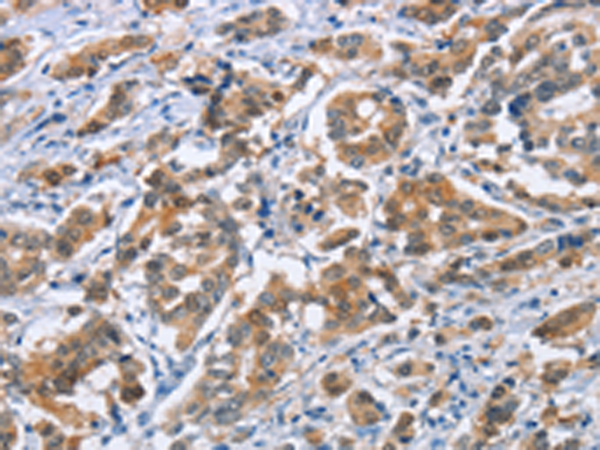
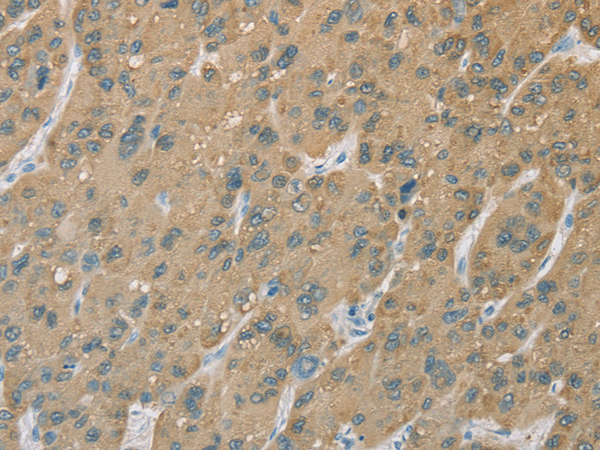

-
分类: 科研抗体货号: P08161别名: LB1; TMAP; se20-10应用: IHC反应种属: Human
-
分类: 科研抗体货号: P08160别名: p90; KIAA1524应用: WB反应种属: Human, Mouse
-
分类: 科研抗体货号: P08178别名: RBP6; CRABP-II应用: IHC反应种属: Human, Mouse, Rat
-
分类: 科研抗体货号: P08158别名: DRE2; PRO0915; Anamorsin; 2810413N20Rik应用: WB,IHC反应种属: Human
-
分类: 科研抗体货号: P08195别名: CPE1; CYP2E; P450-J; P450C2E应用: WB,IHC反应种属: Human, Mouse, Rat
-
分类: 科研抗体货号: P08177别名: NAR; NEB1; CPSF30应用: WB反应种属: Human, Mouse, Rat
-
分类: 科研抗体货号: P08157别名:应用: WB,IHC反应种属: Human, Mouse
-
分类: 科研抗体货号: P08194别名: CPC9; CYP2C; CYP2C10; CYPIIC9; P450IIC9应用: IHC反应种属: Human
-
分类: 科研抗体货号: P08176别名: PLA2G4; cPLA2-alpha应用: IHC反应种属: Human, Mouse, Rat
-
分类: 科研抗体货号: P08155别名: PCH8; CHMP1; PRSM1; PCOLN3; VPS46A; VPS46-1应用: WB,IHC反应种属: Human, Mouse

鄂公网安备42018502007531号
鄂公网安备42018502007531号

